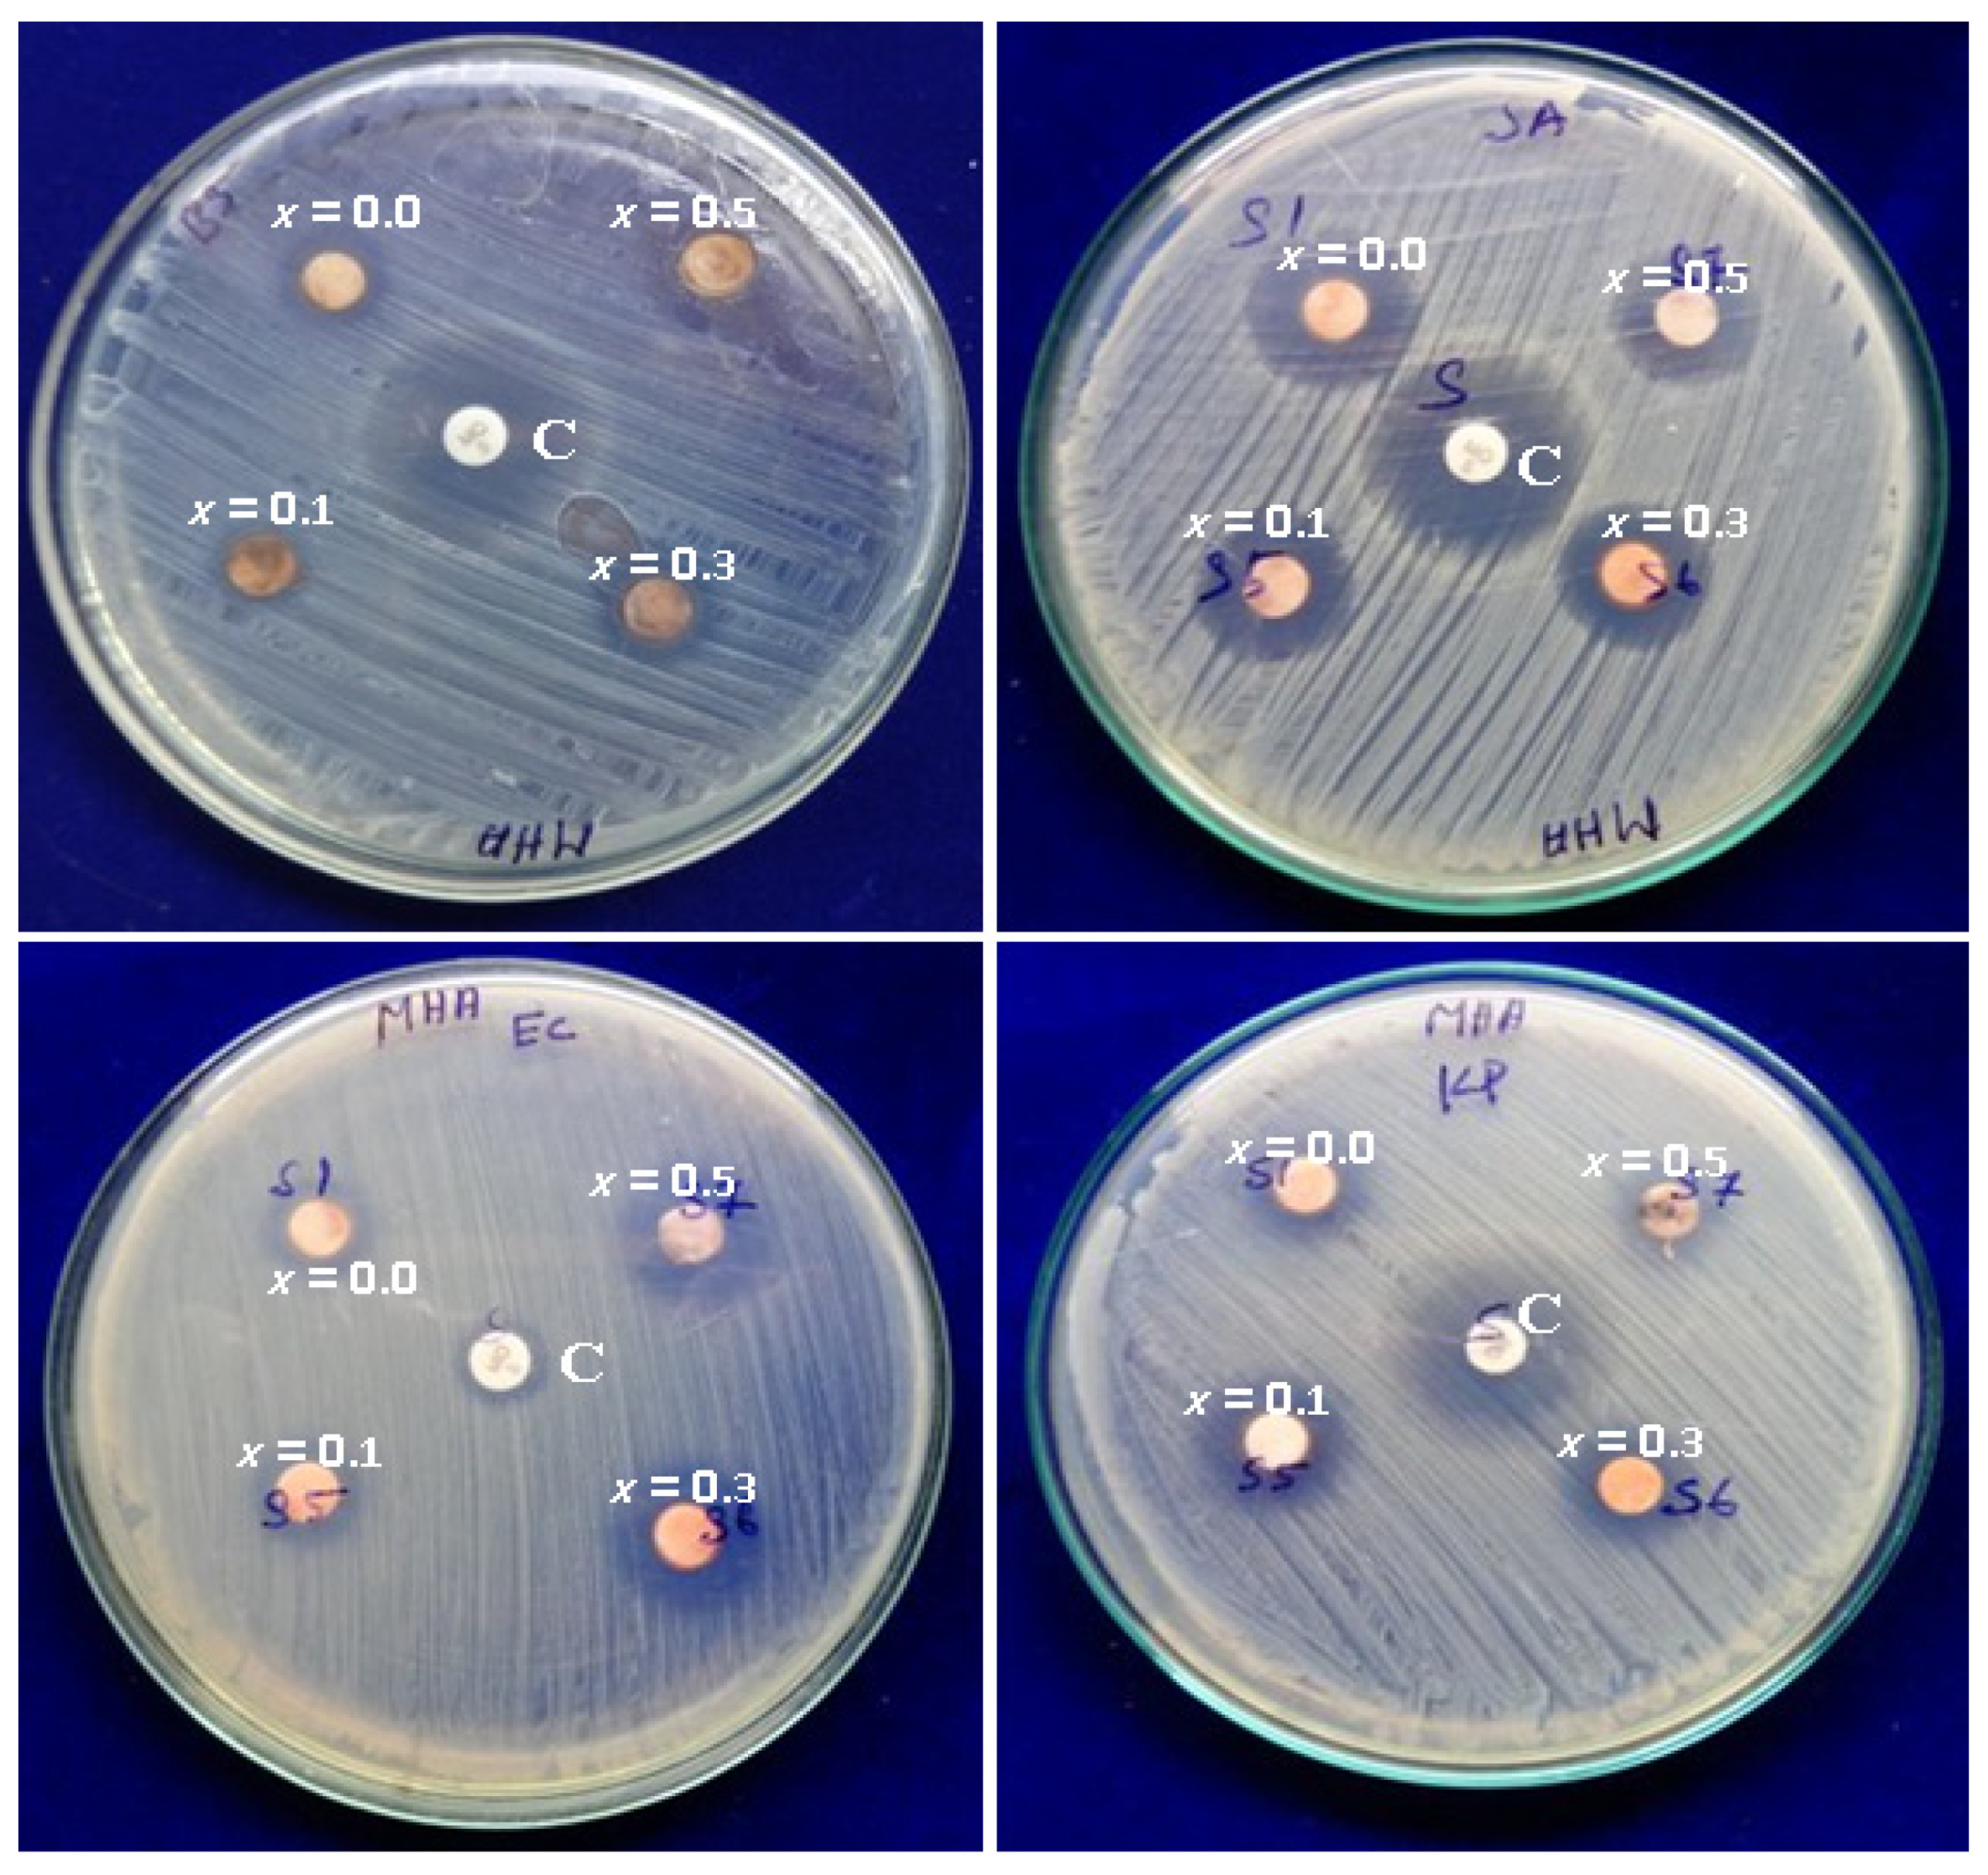
Crystals 12 00268 g011

Influence of Ce3+ on the Structural, Morphological, Magnetic, Photocatalytic and Antibacterial Properties of Spinel MnFe2O4 Nanocrystallites Prepared by the Combustion Route
Abstract
:1. Introduction
2. Experimental Procedure
2.1. Synthesis of Spinel MnCexFe2−xO4 Nanocrystallites
2.2. Characteri Zation Techniques
2.3. Photocatalytic Evaluation
2.4. Antibacterial Activity
3. Results and Discussion
3.1. Structural Analysis
3.2. Fourier Transform Infrared (FT-IR) Spectral Analysis
3.3. HR-SEM Analysis
3.4. HR-TEM Analysis
3.5. Magnetization Analysis
3.6. Photocatalytic Studies
3.7. Kinetic Studies
3.8. Photocatalytic Degradation Mechanism
3.9. Antibacterial Studies
4. Conclusions
Author Contributions
Funding
Institutional Review Board Statement
Informed Consent Statement
Data Availability Statement
Acknowledgments
Conflicts of Interest
References
- Waqas, H.; Qureshi, A.; Subhan, K.; Shahzad, M. Nanograin Mn–Zn ferrite smart cores to miniaturize electronic devices. Ceram. Int. 2012, 38, 1235–1240. [Google Scholar] [CrossRef]
- Murugan, E.; Vimala, G. Effective functionalization of multiwalled carbon nanotube with amphiphilic poly(propyleneimine) dendrimer carrying silver nanoparticles for better dispersability and antimicrobial activity. J. Colloid Interface Sci. 2011, 357, 354–365. [Google Scholar] [CrossRef] [PubMed]
- Pubby, K.; Narang, S.B. Influence of grain size and porosity on X-band properties of Mn-Zr substituted Ni-Co ferrites. Mater. Lett. 2019, 244, 186–191. [Google Scholar] [CrossRef]
- Sonia, M.M.L.; Anand, S.; Blessi, S.; Pauline, S.; Manikandan, A. Effect of surfactants (PVB/EDTA/CTAB) assisted sol-gel synthesis on structural, magnetic and dielectric properties of NiFe2O4 nanoparticles. Ceram. Int. 2018, 44, 22068–22079. [Google Scholar] [CrossRef]
- Murugan, E.; Rangasamy, R. Development of stable pollution free TiO2/Au nanoparticle immobilized green photo catalyst for degradation of methyl orange. J. Biomed. Nanotechnol. 2011, 7, 225–228. [Google Scholar] [CrossRef]
- Praveena, K.; Sadhana, K.; Bharadwaj, S.; Murthy, S.R. Fabrication of dc–dc converter using nanocrystalline Mn–Zn fer-rites. Mater. Res. Innov. 2010, 14, 102–106. [Google Scholar] [CrossRef]
- Huang, R.; Zhang, D.; Tseng, K.-J. Determination of Dimension-Independent Magnetic and Dielectric Properties for Mn–Zn Ferrite Cores and Its EMI Applications. IEEE Trans. Electromagn. Compat. 2008, 50, 597–602. [Google Scholar] [CrossRef]
- Murugan, E.; Santhoshkumar, S.; Govindaraju, S.; Palanichamy, M. Silver nanoparticles decorated g-C3N4: An efficient SERS substrate for monitoring catalytic reduction and selective Hg2+ions detection. Spectrochim. Acta Part A Mol. Biomol. Spectrosc. 2021, 246, 119036. [Google Scholar] [CrossRef]
- Xie, T.; Li, H.; Liu, C.; Yang, J.; Xiao, T.; Xu, L. Magnetic Photocatalyst BiVO4/Mn-Zn ferrite/Reduced Graphene Oxide: Synthesis Strategy and Its Highly Photocatalytic Activity. Nanomaterials 2018, 8, 380. [Google Scholar] [CrossRef] [PubMed]
- Shen, C.Q.; Ji, H.N.; Wu, J.; Zhu, N.; Niu, J.Q.; Li, H.D.; Niu, X.B. Synthesis and Characterization of MnZn Ferrite Nano-particles for Biomedical Applications. In Proceedings of the IEEE International Conference on Applied Superconductivity and Electromagnetic Devices (ASEMD), Beijing, China, 15–18 April 2018; pp. 1–2. [Google Scholar]
- Anwar, A.; Zulfiqar, S.; Yousuf, M.A.; Ragab, S.A.; Khan, M.A.; Shakir, I.; Warsi, M.F. Impact of rare earth Dy+3 cations on the various parameters of nanocrystalline nickel spinel ferrite. J. Mater. Res. Technol. 2020, 9, 5313–5325. [Google Scholar] [CrossRef]
- Shah, J.; Kotnala, R.K.; Singh, B.; Kishan, H. Microstructure-dependent humidity sensitivity of porous MgFe2O4–CeO2 ce-ramic. Sens. Actuators B Chem. 2007, 128, 306–311. [Google Scholar] [CrossRef]
- Khomskii, D. Multiferroics: Different ways to combine magnetism and ferroelectricity. J. Magn. Magn. Mater. 2006, 306, 1–8. [Google Scholar] [CrossRef]
- Yin, L.; Mi, W. Progress in BiFeO3-based heterostructures: Materials, properties and applications. Nanoscale 2020, 12, 477–523. [Google Scholar] [CrossRef] [PubMed]
- Hou, X.; Wang, X.; Mi, W. Progress in Fe3O4-based multiferroic heterostructures. J. Alloys Compd. 2018, 765, 1127–1138. [Google Scholar] [CrossRef]
- Back, M.; Trave, E.; Marin, R.; Marzocco, N.; Cristofori, D.; Riello, P. Energy Transfer in Bi- and Er-Codoped Y2O3 Nano-crystals: An Effective System for Rare Earth Fluorescence Enhancement. J. Phys. Chem. A 2014, 118, 30071–30078. [Google Scholar]
- Pal, M.; Brahma, P.; Chakravorty, D. Magnetic and electrical properties of nickel-zinc ferrites doped with bismuth oxide. J. Magn. Magn. Mater. 1996, 152, 370–374. [Google Scholar] [CrossRef]
- Pal, M.; Brahrma, P.; Chakravorty, D. AC conductivity in bismuth oxide doped nickel-zinc ferrites. J. Phys. Soc. Jpn. 1998, 67, 2847–2851. [Google Scholar] [CrossRef]
- Angadi, V.J.; Manjunatha, K.; Kubrin, S.; Kozakov, A.; Kochur, A.; Nikolskii, A.; Petrov, I.; Shevtsova, S.; Ayachit, N. Crystal structure, valence state of ions and magnetic properties of HoFeO3 and HoFe0.8Sc0.2O3 nanoparticles from X-ray diffraction, X-ray photoelectron, and Mössbauer spectroscopy data. J. Alloys Compd. 2020, 842, 155805. [Google Scholar] [CrossRef]
- Sathisha, I.C.; Manjunatha, K.; Angadi, V.J.; Reddy, R.K. Structural, Microstructural, Electrical, and Magnetic Properties of CuFe2-(x + y) EuxScyO4 (where x and y vary from 0 to 0.03) Nanoparticles. J. Supercond. Nov. Magn. 2020, 33, 3963–3973. [Google Scholar] [CrossRef]
- Manjunatha, K.; Angadi, V.J.; Rajaramakrishna, R.; Pasha, U.M. Role of 5 mol% Mg-Ni on the Structural and Magnetic Properties of Cobalt Chromates Crystallites Prepared by Solution Combustion Technique. J. Supercond. Nov. Magn. 2020, 33, 2861–2866. [Google Scholar] [CrossRef]
- Ding, F.; Lin, J.; Wu, T.; Zhong, H. Scanning electron microscopy (SEM), energy-dispersive X-ray (EDX) spectroscopy and nuclear radiation shielding properties of [α-Fe3+O(OH)]-doped lithium borate glasses. Appl. Phys. A 2020, 126, 221. [Google Scholar] [CrossRef]
- Thakur, P.; Chahar, D.; Taneja, S.; Bhalla, N.; Thakur, A. A review on MnZn ferrites: Synthesis, characterization and applications. Ceram. Int. 2020, 46, 15740–15763. [Google Scholar] [CrossRef] [PubMed]
- Foroutan, R.; Mohammadi, R.; MousaKhanloo, F.; Sahebi, S.; Ramavandi, B.; Kumar, P.S.; Vardhan, K.H. Performance of montmorillonite/graphene oxide/CoFe2O4 as a magnetic and recyclable nanocomposite for cleaning methyl violet dye-laden wastewater. Adv. Powder Technol. 2020, 31, 3993–4004. [Google Scholar] [CrossRef]
- Boushehrian, M.M.; Esmaeili, H.; Foroutan, R. Ultrasonic assisted synthesis of Kao-lin/CuFe2O4 nanocomposite for removing cationic dyes from aqueous media. J. Environ. Chem. Eng. 2020, 8, 103869. [Google Scholar] [CrossRef]
- Foroutan, R.; Peighambardoust, S.J.; Esvandi, Z.; Khatooni, H.; Ramavandi, B. Evaluation of two cationic dyes removal from aqueous environments using CNT/MgO/CuFe2O4 magnetic composite powder: A comparative study. J. Environ. Chem. Eng. 2021, 9, 104752. [Google Scholar] [CrossRef]
- Foroutan, R.; Mohammadi, R.; Ahmadi, A.; Bikhabar, G.; Babaei, F.; Ramavandi, B. Impact of ZnO and Fe3O4 magnetic nanoscale on the methyl violet 2B removal efficiency of the activated carbon oak wood. Chemosphere 2022, 286, 131632. [Google Scholar] [CrossRef]
- Foroutan, R.; Peighambardoust, S.J.; Hemmati, S.; Khatooni, H.; Ramavandi, B. Preparation of clinoptilo-lite/starch/CoFe2O4 magnetic nanocomposite powder and its elimination properties for cationic dyes from water and wastewater. Int. J. Biol. Macromol. 2021, 189, 432–442. [Google Scholar] [CrossRef]
- Sathisha, I.C.; Manjunatha, K.; Bajorek, A.; Babu, B.R.; Chethan, B.; Reddy, T.R.K.; Ravikiran, Y.T.; Angadi, V.J. Enhanced humidity sensing and magnetic properties of bismuth doped copper ferrites for humidity sensor applications. J. Alloys Compd. 2020, 848, 156577. [Google Scholar] [CrossRef]
- Shah, J.; Arora, M.; Purohit, L.; Kotnala, R. Significant increase in humidity sensing characteristics of praseodymium doped magnesium ferrite. Sens. Actuators A Phys. 2011, 167, 332–337. [Google Scholar] [CrossRef]
- Li, Y.; Fan, K.; Ban, H.; Yang, M. Detection of very low humidity using polyelectrolyte/graphene bilayer humidity sensors. Sensors Actuators B Chem. 2016, 222, 151–158. [Google Scholar] [CrossRef]
- Chen, Z.; Lu, C. Humidity Sensors: A Review of Materials and Mechanisms. Sens. Lett. 2005, 3, 274–295. [Google Scholar] [CrossRef]
- Sunilkumar, A.; Manjunatha, S.; Chethan, B.; Ravikiran, Y.; Machappa, T. Polypyrrole–Tantalum disulfide composite: An efficient material for fabrication of room temperature operable humidity sensor. Sens. Actuators A Phys. 2019, 298, 111593. [Google Scholar] [CrossRef]
- Zhang, D.; Wang, D.; Li, P.; Zhou, X.; Zong, X.; Dong, G. Facile fabrication of high-performance QCM humidity sensor based on layer-by-layer self-assembled polyaniline/graphene oxide nanocomposite film. Sens. Actuators B Chem. 2018, 255, 1869–1877. [Google Scholar] [CrossRef]
- Ravinder, D.; Kumar, K.V. Dielectric behaviour of erbium substituted Mn-Zn ferrites. Bull. Mater. Sci. 2001, 24, 505–509. [Google Scholar] [CrossRef]
- Lumina Sonia, M.M.; Anand, S.; Vinosel, V.M.; Janifer, M.A.; Pauline, S.; Manikandan, A. Effect of lattice strain on structure, morphology and magneto-dielectric properties of NiGdxFe2−xO4 ferrite nano-crystallites synthesized by sol-gel route. J. Magn. Magn. Mater. 2018, 466, 238–251. [Google Scholar] [CrossRef]
- Velanganni, S.; Manikandan, A.; Prince, J.J.; Mohan, C.N.; Thiruneelakandan, R. Nanostructured ZnO coated Bi2S3 thin films: Enhanced photocatalytic degradation of methylene blue dye. Phys. B Condens. Matter 2018, 545, 383–389. [Google Scholar] [CrossRef]
- Baykal, A.; Guner, S.; Gungunes, H.; Batoo, K.M.; Amir, M.; Manikandan, A. Magneto Optical Properties and Hyperfine Interactions of Cr3+ Ion Substituted Copper Ferrite Nanoparticles. J. Inorg. Organomet. Polym. Mater. 2018, 28, 2533–2544. [Google Scholar] [CrossRef]
- Amir, M.; Gungunes, H.; Slimani, Y.; Tashkandi, N.; El Sayed, H.S.; Aldakheel, F.; Sertkol, M.; Sözeri, H.; Manikandan, A.; Ercan, I.; et al. Mössbauer Studies and Magnetic Properties of Cubic CuFe2O4 Nanoparticles. J. Supercond. Nov. Magn. 2018, 32, 557–564. [Google Scholar] [CrossRef]
- Slimani, Y.; Güngüneş, H.; Nawaz, M.; Manikandan, A.; El Sayed, H.; Almessiere, M.; Sözeri, H.; Shirsath, S.; Ercan, I.; Baykal, A. Magneto-optical and microstructural properties of spinel cubic copper ferrites with Li-Al co-substitution. Ceram. Int. 2018, 44, 14242–14250. [Google Scholar] [CrossRef]
- Lynda, I.J.C.; Durka, M.; Dinesh, A.; Manikandan, A.; Jaganathan, S.K.; Baykal, A.; Antony, S.A. Enhanced Magneto-optical and Photocatalytic Properties of Ferromagnetic Mg1−yNiyFe2O4 (0.0 ≤ y ≤ 1.0) Spinel Nano-ferrites. J. Supercond. Nov. Magn. 2018, 31, 3637–3647. [Google Scholar] [CrossRef]
- Esvandi, Z.; Foroutan, R.; Peighambardoust, S.J.; Akbari, A.; Ramavandi, B. Uptake of anionic and cationic dyes from water using natural clay and clay/starch/MnFe2O4 magnetic nanocomposite. Surf. Interfaces 2020, 21, 100754. [Google Scholar] [CrossRef]
- Amir, M.; Gungunes, H.; Baykal, A.; Almessiere, M.A.; Sözeri, H.; Ercan, I.; Sertkol, M.; Asiri, S.; Manikandan, A. Effect of an-nealing temperature on Magnetic and Mossbauer properties of ZnFe2O4 nanoparticles by sol-gel approach. J. Supercond. Nov. Magn. 2018, 31, 3347–3356. [Google Scholar] [CrossRef]
- Abraham, A.G.; Manikandan, A.; Manikandan, E.; Vadivel, S.; Jaganathan, S.K.; Baykal, A.; Renganathan, P.S. Enhanced magneto-optical and photo-catalytic properties of transition metal cobalt (Co2+ ions) doped spinel MgFe2O4 ferrite nano-composites. J. Magn. Magn. Mater. 2018, 452, 380–388. [Google Scholar] [CrossRef]
- Ratnayake, S.; Mantilaka, M.; Sandaruwan, C.; Dahanayake, D.; Murugan, E.; Kumar, S.; Amaratunga, G.; de Silva, K.N. Carbon quantum dots-decorated nano-zirconia: A highly efficient photocatalyst. Appl. Catal. A Gen. 2019, 570, 23–30. [Google Scholar] [CrossRef]
- Abraham, A.G.; Manikandan, A.; Manikandan, E.; Jaganathan, S.K.; Baykal, A.; Renganathan, P. Enhanced Opto-Magneto Properties of NixMg1−xFe2O4 (0.0 ≤ x ≤ 1.0) Ferrites Nano-Catalysts. J. Nanoelect. Optoelect. 2017, 12, 1326–1333. [Google Scholar] [CrossRef]
- Muthukrishnaraj, A.; Al-Zahrani, S.; Al Otaibi, A.; Kalaivani, S.; Manikandan, A.; Balasubramanian, N.; Bilgrami, A.; Ahamed, M.; Khan, A.; Asiri, A.; et al. Enhanced Photocatalytic Activity of Cu2O Cabbage/RGO Nanocomposites under Visible Light Irradiation. Polymers 2021, 13, 1712. [Google Scholar] [CrossRef]
- Sri, V.S.P.S.; Manikandan, A.; Mathankumar, M.; Tamizhselvi, R.; George, M.; Murugaiah, K.; Kashmery, H.A.; Al-Zahrani, S.A.; Puttegowda, M.; Khan, A.; et al. Unveiling the photosensitive, mechanical and magnetic properties of amorphous iron nanoparticles with its application towards decontamination of water and cancer treatment. J. Mater. Res. Technol. 2021, 15, 99–118. [Google Scholar]
- Vanitha, M.; Ramachandran, G.; Manikandan, A.; Slimani, Y.; Almessiere, M.A.; Baykal, A.; Dash, C.S. Effect of Sr2+ Ion–Substituted Nickel Ferrite Nanoparticles Prepared by a Simple Microwave Combustion Method. J. Supercond. Nov. Magn. 2021, 34, 971–980. [Google Scholar] [CrossRef]
- Vinosha, P.A.; Manikandan, A.; Ceicilia, A.S.J.; Dinesh, A.; Nirmala, G.F.; Preetha, A.C.; Slimani, Y.; Almessiere, M.; Baykal, A.; Xavier, B. Review on recent advances of zinc substituted cobalt ferrite nanoparticles: Synthesis characterization and diverse applications. Ceram. Int. 2021, 47, 10512–10535. [Google Scholar] [CrossRef]
- Vinosha, P.A.; Manikandan, A.; Ragu, R.; Dinesh, A.; Thanrasu, K.; Slimani, Y.; Baykal, A.; Xavier, B. Impact of nickel substitution on structure, magneto-optical, electrical and acoustical properties of cobalt ferrite nanoparticles. J. Alloys Compd. 2021, 857, 157517. [Google Scholar] [CrossRef]
- Vinosha, P.A.; Manikandan, A.; Preetha, A.C.; Dinesh, A.; Slimani, Y.; Almessiere, M.A.; Baykal, A.; Xavier, B.; Nirmala, G.F. Review on recent advances of synthesis, magnetic properties and water treatment applications of cobalt ferrite nanoparticles and nanocomposites. J. Supercond. Nov. Magn. 2021, 34, 995–1018. [Google Scholar] [CrossRef]
- Renuga, R.; Manikandan, A.; Mary, J.A.; Muthukrishnaraj, A.; Khan, A.; Srinivasan, S.; Al Alwan, B.A.M.; Khedher, K.M. Enhanced Magneto-Optical, Morphological, and Photocatalytic Properties of Nickel-Substituted SnO2 Nano-particles. J. Supercond. Nov. Magn. 2021, 34, 825–836. [Google Scholar] [CrossRef]
- Vinosha, P.A.; Manikandan, A.; Ragu, R.; Dinesh, A.; Paulraj, P.; Slimani, Y.; Almessiere, M.; Baykal, A.; Madhavan, J.; Xavier, B.; et al. Exploring the influence of varying pH on structural, electro-optical, magnetic and photo-Fenton properties of mesoporous ZnFe2O4 nanocrystals. Environ. Pollut. 2021, 272, 115983. [Google Scholar] [CrossRef] [PubMed]
- TMaksoud, M.A.; Fahim, R.A.; Bedir, A.G.; Osman, A.I.; Abouelela, M.M.; El-Sayyad, G.S.; Abd Elkodous, M.; Mahmoud, A.S.; Rabee, M.M.; Ala’a, H.; et al. Baykal, Nickel sub-stituted MgFe2O4 nanoparticles via co-precipitation method for photocatalytic applications. Phys. B Condens. Matter. 2021, 606, 412660. [Google Scholar]
- Senthil, R.A.; Osman, S.; Pan, J.; Khan, A.; Yang, V.; Kumar, T.R.; Sun, Y.; Lin, Y.; Liu, X.; Manikandan, A. One-pot preparation of AgBr/α-Ag2WO4 composites with superior photocatalytic activity under visible-light irradiation. Colloid Surf. A Physicochem. Eng. Aspect. 2020, 586, 124079. [Google Scholar] [CrossRef]
- Muthukrishnaraj, A.; Kalaivani, S.S.; Manikandan, A.; Kavitha, H.P.; Srinivasan, R.; Balasubramanian, N. Sonochemical syn-thesis and visible light induced photocatalytic property of reduced graphene oxide@ ZnO hexagonal hollow rod nano-composite. J. Alloys Compd. 2020, 83625, 155377. [Google Scholar] [CrossRef]
- Rathinavel, S.; Panda, D.; Manikandan, A. Synthesis and characterization of MgFe2O4 and MgFe2O4/rGO nanocomposites for the photocatalytic degradation of methylene blue. Inorg. Nano-Met. Chem. 2021, 51, 210–217. [Google Scholar] [CrossRef]
- Senthil, R.A.; Osman, S.; Pan, J.; Sun, Y.; Kumar, T.R.; Manikandan, A. A facile hydrothermal synthesis of visible-light responsive BiFeWO6/MoS2 composite as superior photocatalyst for degradation of organic pollutants. Ceram. Int. 2019, 45, 18683–18690. [Google Scholar] [CrossRef]
- George, M.; Ajeesha, T.L.; Manikandan, A.; Anantharaman, A.; Jansi, R.S.; Kumar, E.R.; Slimani, Y.; Almessiere, M.A.; Baykal, A. Evaluation of Cu-MgFe2O4 spinel nanoparticles for photocatalytic and antimicrobial activates. J. Phys. Chem. Solids 2021, 153, 110010. [Google Scholar] [CrossRef]
- Elayakumar, K.; Manikandan, A.; Dinesh, A.; Thanrasu, K.; Raja, K.K.; Kumar, R.T.; Slimani, Y.; Jaganathan, S.K.; Baykal, A. Enhanced magnetic property and antibacterial biomedical activity of Ce3+ doped CuFe2O4 spinel nanoparticles synthesized by sol-gel method. J. Magn. Magn. Mater. 2019, 478, 140–147. [Google Scholar] [CrossRef]
- Babitha, N.; Priya, L.S.; Christy, S.R.; Manikandan, A.; Dinesh, A.; Durka, M.; Arunadevi, S. Enhanced Antibacterial Activity and Photo-Catalytic Properties of ZnO Nanoparticles: Pedalium Murex Plant Extract-Assisted Synthesis. J. Nanosci. Nanotechnol. 2019, 19, 2888–2894. [Google Scholar] [CrossRef] [PubMed]
- Al-Jameel, S.S.; Rehman, S.; Almessiere, M.A.; Khan, F.A.; Slimani, Y.; Al-Saleh, N.S.; Manikandan, A.; Al-Suhaimi, E.A.; Baykal, A. Anti-microbial and anti-cancer activities of Mn0.5Zn0.5DyxFe2−xO4 (x ≤ 0.1) nanoparticles. Artif. Cells Nanomed. Biotechnol. 2021, 49, 493–499. [Google Scholar] [CrossRef] [PubMed]
- Elayakumar, K.; Dinesh, A.; Manikandan, A.; Palanivelu, M.; Kavitha, G.; Prakash, S.; Kumar, R.T.; Jaganathan, S.K.; Baykal, A. Structural, morphological, enhanced magnetic properties and antibacterial bio-medical activity of rare earth element (REE) Cerium (Ce3+) doped CoFe2O4 nanoparticles. J. Magn. Magn. Mater. 2019, 476, 157–165. [Google Scholar] [CrossRef]

| Sample Code | L (nm) by Debye Scherrer | D (nm) by Williamson–Hall Plot | a (Å) |
|---|---|---|---|
| MnFe2O4 | 26.48 | 27.13 | 8.359 |
| MnCe0.1Fe1.9O4 | 25.76 | 26.47 | 8.362 |
| MnCe0.3Fe1.7O4 | 23.98 | 24.56 | 8.375 |
| MnCe0.5Fe1.5O4 | 24.33 | 25.84 | 8.386 |
| Sample Code | Hc, (Oe) | Ms (emu/g) | Mr (emu/g) |
|---|---|---|---|
| MnFe2O4 | 260.72 | 17.86 | 5.757 |
| MnCe0.1Fe1.9O4 | 278.65 | 24.39 | 6.362 |
| MnCe0.3Fe1.7O4 | 292.44 | 27.65 | 7.521 |
| MnCe0.5Fe1.5O4 | 302.25 | 31.22 | 8.533 |
| Sample | MB Dye Degradation Efficiency (%) |
|---|---|
| Blank | 5.85 |
| MnFe2O4 | 68.66 |
| MnCe0.1Fe1.9O4 | 78.95 |
| MnCe0.3Fe1.7O4 | 91.53 |
| MnCe0.5Fe1.5O4 | 88.56 |
| Samples | k min−1 | ||||
|---|---|---|---|---|---|
| Blank | MnFe2O4 | MnCe0.1Fe1.9O4 | MnCe0.3Fe1.7O4 | MnCe0.5Fe1.5O4 | |
| MB | 0 | 0.005 | 0.0126 | 0.0193 | 0.0153 |
| Bacteria | Zone of Inhibition (mm, Diameter) | ||||
|---|---|---|---|---|---|
| Control | x = 0.0 | x = 0.1 | x = 0.3 | x = 0.5 | |
| B. subtilis | 14 | 12 | 14 | 16 | 16 |
| S. aureus | 14 | 12 | 14 | 17 | 16 |
| E. coli | 10 | 12 | 14 | 17 | 16 |
| K. pneumoniae | 16 | 15 | 17 | 20 | 19 |
Publisher’s Note: MDPI stays neutral with regard to jurisdictional claims in published maps and institutional affiliations. |
© 2022 by the authors. Licensee MDPI, Basel, Switzerland. This article is an open access article distributed under the terms and conditions of the Creative Commons Attribution (CC BY) license (https://creativecommons.org/licenses/by/4.0/).
Share and Cite
Al-Zahrani, S.A.; Manikandan, A.; Thanrasu, K.; Dinesh, A.; Raja, K.K.; Almessiere, M.A.; Slimani, Y.; Baykal, A.; Bhuminathan, S.; Jayesh, S.R.; et al. Influence of Ce3+ on the Structural, Morphological, Magnetic, Photocatalytic and Antibacterial Properties of Spinel MnFe2O4 Nanocrystallites Prepared by the Combustion Route. Crystals 2022, 12, 268. https://doi.org/10.3390/cryst12020268
Al-Zahrani SA, Manikandan A, Thanrasu K, Dinesh A, Raja KK, Almessiere MA, Slimani Y, Baykal A, Bhuminathan S, Jayesh SR, et al. Influence of Ce3+ on the Structural, Morphological, Magnetic, Photocatalytic and Antibacterial Properties of Spinel MnFe2O4 Nanocrystallites Prepared by the Combustion Route. Crystals. 2022; 12(2):268. https://doi.org/10.3390/cryst12020268
Chicago/Turabian StyleAl-Zahrani, Salma A., A. Manikandan, K. Thanrasu, A. Dinesh, K. Kanmani Raja, M. A. Almessiere, Y. Slimani, A. Baykal, S. Bhuminathan, S. Raghavendra Jayesh, and et al. 2022. "Influence of Ce3+ on the Structural, Morphological, Magnetic, Photocatalytic and Antibacterial Properties of Spinel MnFe2O4 Nanocrystallites Prepared by the Combustion Route" Crystals 12, no. 2: 268. https://doi.org/10.3390/cryst12020268
APA StyleAl-Zahrani, S. A., Manikandan, A., Thanrasu, K., Dinesh, A., Raja, K. K., Almessiere, M. A., Slimani, Y., Baykal, A., Bhuminathan, S., Jayesh, S. R., Ahmed, J., Alorfi, H. S., Hussein, M. A., Khan, I., & Khan, A. (2022). Influence of Ce3+ on the Structural, Morphological, Magnetic, Photocatalytic and Antibacterial Properties of Spinel MnFe2O4 Nanocrystallites Prepared by the Combustion Route. Crystals, 12(2), 268. https://doi.org/10.3390/cryst12020268

